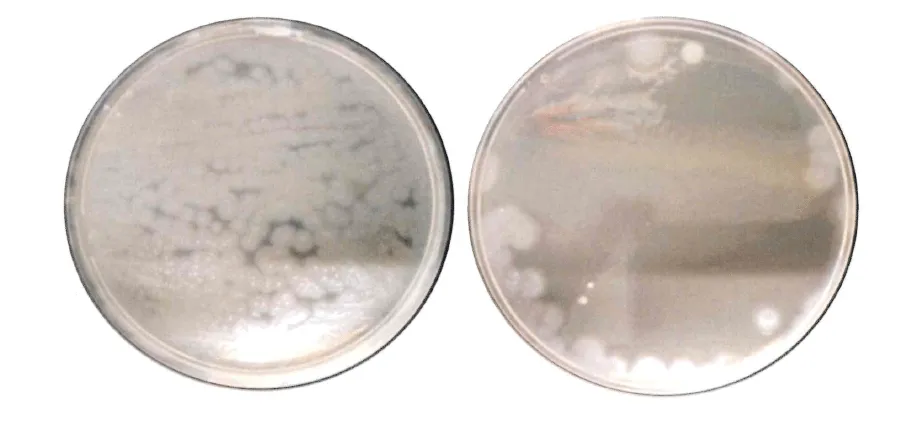

TRULY MOTIVATED TO DOMINATE THEIR MARKET












BEFORE vs. AFTER
In the first image on the left, you can see the plate completely overrun by colonies of Staphylococcus aureus — one of the most dangerous bacteria for human health — often found on nozzles and keypads of contaminated water dispensers.
In the second image, here’s the same area after TYFON’s automatic intervention: no visible colonies, no bacterial growth. Just a sterile, safe field.
No other UV-outlet system or standard ozone technology can achieve such a visibly complete level of neutralization.

BEFORE vs. AFTER
And that’s not all. Take a look at the effects on Pseudomonas aeruginosa and Saccharomyces cerevisiae — invisible yet dangerous bacteria that threaten your customers' health and your brand's reputation.
With TYFON, these harmful contaminants are completely eliminated right at the nozzle, with no noise, no smell, and no need for manual intervention.

BEFORE vs. AFTER
On the left: the devastating attack of Pseudomonas aeruginosa — a full-blown bacterial explosion covering every millimeter of the petri dish.
It looks like a contaminated battlefield — and it’s exactly what could be happening every time your client drinks from an unprotected dispenser.
On the right: after TYFON’s effect — the dish is clear, sterile, pure.
No growth. No contamination. No threat.
Certified clinical result by the Department of Medicine and Surgery at the University of Milan-Bicocca.
And now ask yourself: what are your clients really drinking?

BEFORE vs. AFTER
Look at the image on the left: the green color shows the uncontrolled proliferation of Staphylococcus aureus.
A miniature epidemic, grown in just two hours.
Now look to the right.
With Tyfon, it doesn’t exist.
Same test. Same bacteria.
But with Tyfon active… the surface is clear.
It’s disarming. It’s shocking.
The difference between these two petri dishes is the same as the difference between a 5-star review and a legal call.
And when your client finds out what they’ve been drinking… they won’t be a client anymore.

Paolo Tesi is not just someone in the industry.
He was the first in the world to introduce ozone sanitation in water systems.
He invented the chip card system for smart dispenser management.
He was the first to bring touch screen technology to the water treatment world.
Three companies founded from scratch, brought to success, and sold to industrial groups.
And today Paolo Tesi leads his fourth venture: Onnwater®.
I’m not telling you all this to glorify Paolo.
Ignoring Retro-Contamination Could Be the Mistake That Destroys Your Water Dispenser Business






Bacterial back-contamination isn’t a future threat.
It’s happening. Even now. Even where you least expect it...
it gives no warning.
Like a toxic stain that can’t be removed.
Make you lose strategic clients.
because of an invisible mistake.
keypads and buttons of water dispensers, drip trays, and water outlet points (dispensing nozzles).
Touched by dirty hands. By contaminated bottles.
Perfect for hosting colonies of bacteria.
a slimy layer that feeds them, protects them…
and makes them practically invincible.
From the dispensing point — where water has just been filtered —
they penetrate the system…
and contaminate it from the inside. After the water has been filtered.
can’t prevent back-contamination because it happens after filtration.
The customer trusts it.
Without knowing it.
You’ve just put their health at risk.
Compromised your work, your reputation, your company.
They’re just… insufficient.
Because many systems are designed by former engineers from automotive, beverage, or industrial refrigeration sectors…
So what happens?
Recycle old schemes.
Hidden behind modern labels.
Ineffective solutions that look new. But aren’t.
Meanwhile…
Systems that don’t set you apart.
Systems that force you to justify a higher price—
without having anything more to offer.
And so…
Who question you.
Who compare your dispensers to similar but cheaper ones.
And you lose.
Revenue.
Time.
Vulnerable.
Not because of your mistake.
It’s not fair.
And it’s a reality that won’t wait.
Against Retro-Contamination:
But now we know an uncomfortable truth that few dare to admit:
They have to stay on 24/7 to guarantee their effectiveness.
But not just anyone can do it.
It takes experience. It takes time. It takes the right technician.
And when something goes wrong—maybe right in front of the customer—you lose face before you even lose the contract.
Dark corners, uneven surfaces, invisible micro-spaces…
perfect hiding spots for bacteria.
Just one untreated area… is enough to contaminate everything else.
Which makes them illegal. And dangerous.
In direct contact with water.
A simple fault like this… and you’re front-page news.
And now that you know…
In just a few seconds, I’ll explain exactly what makes Tyfon®
An invisible system.
Automatic. Infallible.
You don’t need to configure it. You don’t need to monitor it. You don’t even need to remember it exists.
Always there.
Always active.
Always by your side.
And it strikes exactly where bacteria love to hide:
Three weak points.
Three overlooked areas.
Three hidden risks that are silently putting your reputation at stake.
Before it infects.
Before it ruins everything you’ve worked to build.
Zero maintenance.
Zero impact on taste.
Zero signs of its presence.
Even when you’ve forgotten it’s there.
- Active ions
Lethal to germs.
Harmless to humans.
Exceptional for your business.
And the silent difference between those who hope everything goes well…
Of How TYFON Protects Every Water Dispenser
And Frees You Forever from the Anxiety


How Does TYFON® Work?
I’ll explain that in just a moment…
But first, let me tell you what it’s not.
Because that’s where the surprises begin.
TYFON® is not a traditional ozone generator:
No wires, no bulky attachments, no technical headaches.
You don’t need to install anything externally. No separate connections required.
It’s not a UV lamp at the outlet either:
There’s nothing to replace, no ongoing maintenance.
And it’s not the typical intrusive system that’s hard to explain to your end client.
TYFON® doesn’t alter the taste of water.
It produces no smoke. Emits no odors.
And leaves no toxic residue behind.
It’s not something you “add” to your dispenser.
It’s the opposite.
It’s an integrated part of the dispenser.
Invisible. Intelligent. Autonomous.
And now… here’s what it does.
All it takes is a single, tiny drop of water—
That drop left behind, invisible, on the nozzle after every dispensing.
From there, TYFON® comes to life.
Through a fully patented and automatic process, that micro-residue is transformed into three powerful disinfecting elements:
Ozone, OH radicals, and active ions.
Three active agents.
Three invisible guardians.
Three sworn enemies of contamination.
You don’t need to switch it on.
You don’t need to monitor it.
You don’t even need to remember it’s there.
After every dispensing, as soon as the water stops flowing…
TYFON® activates.
Silently.
Without odors.
Without sound.
And it gets to work.
It protects what no other system even considers:
- The water outlet nozzle
- The drip tray
- The keypad and buttons
Three areas that are always damp, always exposed, and always overlooked.
Three gateways that bacteria use to get back in.
And far too often… they succeed.
But with TYFON®, every attempt is stopped at the source.
Immediately. Instantly
.
The three agents form an invisible shield that neutralizes even the most resistant bacteria:
Staphylococcus aureus, Pseudomonas aeruginosa, Saccharomyces cerevisiae.
You Can Install TYFON. . .
No Tools, No Technician
Physically, TYFON® is a micro-needle—
Invisible to the eye, discreetly embedded inside the dispensing nozzle.
It’s controlled by a smart electronic board inside the dispenser,
which manages everything automatically.
No ongoing maintenance required.
No parts to replace every year.
At most, you’ll clean the nozzle once a year.
Takes just 5 minutes. No tools needed.
Each nozzle has its own TYFON®.
So if your system has dual dispensing,
you get double TYFON® and double protection.
We thought of that too.
TYFON® works in synergy with an in-line UV lamp
rated at 7 liters per minute, installed right at the water inlet of the dispenser.
That UV lamp sterilizes the incoming water.
TYFON® protects the outgoing water.
Even the most filtered water can become contaminated once it enters the dispenser—
which is why the inlet UV lamp is essential to create a powerful synergy…
…and a double layer of protection with TYFON®.

Is It Just Marketing? No. It’s Science. And It’s Irrefutable.
Automatic protection.
The triple barrier against germs.
99.99999% safety
These are not just fancy words.
They are proof. Facts. Clinical verifications.
Because TYFON® is not an advertising promise.
It’s a technology that has passed every test.
And soon you’ll discover a “before and after” that will make you reconsider every other solution you’ve offered so far…
TYFON® is the first — and only — water dispenser system with official clinical certification.
The Department of Medicine and Surgery at the University of Milano-Bicocca — one of the most authoritative scientific centers in Europe — subjected TYFON® to a series of independent, extremely tough tests, under real operating conditions.
What happened?
The three most dangerous bacterial strains were tested:
Staphylococcus aureus – spreads with a sneeze. Survives everywhere.
Pseudomonas aeruginosa – – thrives in moist stagnation. Creates undefeatable biofilms.
Saccharomyces cerevisiae – a resistant fungus, symbol of food contamination.
The result? 99.9999% elimination.
TYFON® wiped out all bacteria. Even at intermediate power.
No noise.
No odors.
Without exceeding the legal ozone limits (<2.5 mg).
All tests were documented on agar plates, photographed, analyzed, verified under the microscope.
See for yourself the before and after images of the deadly effect TYFON® has on the bacteria responsible for retro-contamination.
BEFORE vs. AFTER

BEFORE vs. AFTER
The photos crush every doubt. Before, the bacteria were visible. After TYFON® — gone.
UV lamps at the outlet? They would have left shadow zones.
Classic ozone generators? They would have failed due to technical and legal limits.
Only TYFON® protected the dispenser in every critical millimeter.
And it did it… automatically.
And when you show this to the client? The game changes.
With TYFON® you hold in your hands:
A signed medical certificate.
An official university test.
A visual proof that silences every objection.
You’re no longer just anyone.
You become “the one with clinically proven technology.”
The professional who knows how to protect, differentiate, and sell.
And so:
You justify a higher price, without lowering your head.
You win negotiations where competitors beg for attention.
You attract clients who want the best. Not the cheapest.
With TYFON® you’re not just installing a system
You’re safeguarding your future.
You’re defending your name in the market.
You’re building a company that no retro-contamination can ever put at risk.
Tyfon® helps you close more deals, because no competitor can offer such a unique and certified technology.
Tyfon® lets you increase your margins, offering it as a premium optional—at up to 4x the purchase price.
Tyfon® gives you access to highly sensitive environments—schools, clinics, nursing homes, hospitals—with unmatched medical-grade hygiene.
Tyfon® eliminates the stress of surprise inspections, by protecting the water even after filtration.
Tyfon® safeguards your reputation from unpleasant surprises, complaints, and disputes from end users.
Tyfon® gives you real scientific proof, with a third-party report signed by a university.
Tyfon® empowers your sales team with a powerful lever—easy to explain, memorable, and persuasive.
Tyfon® helps you win more public tenders, especially when hygiene is a key selection criterion.
Tyfon® reduces maintenance needs, avoiding constant replacements, disassembly, and wasted time.
Tyfon® prevents awkward situations with clients, where every technical issue signals uncertainty.
Tyfon® gets you out of the price war, clearly distinguishing you from those who only offer UV lamps.
Tyfon® positions you as the ideal partner for companies seeking safety, innovation, and reliability.
Tyfon® helps you build a brand that's respected, remembered, and chosen—even when cheaper quotes are on the table.
Tyfon® prevents major damage, starting from just one drop of water left in the drip tray.
Tyfon® brings financial stability to your business, peace of mind to your team, and prosperity to your family.

About What Tyfon® Can Really Do for You
In the Real-World Situations Where Your Revenue, Reputation,
About What Tyfon® Can Really Do for You
In the Real-World Situations Where Your Revenue, Reputation,

Between Remaining “One of the Many”… Or Positioning Yourself as a Leader
You want the customer to choose you even if they’re holding three cheaper quotes in their hands.
And Yet More and More Installers
Choose It Every Week.
And Yet More and More Installers
Choose It Every Week.
The real question is NOT “How much does Tyfon® cost?”
The real question is:
How much is your peace of mind worth today?
And your reputation in the market?
How much is it worth to KNOW (not just hope)
that every dispenser you install is completely shielded from bacteria?
That no customer can ever accuse you.
That no test can ever damage your image.
That no contract or tender will slip away because of technical uncertainty.
That you will never again be excluded from hospitals, schools, or clinics…
just because you couldn’t prove you had real protection against back-contamination.
Here’s the point.
How much is it worth to have in your hands the only system in the world...
…certified by a university medical-surgical department.
…designed to make you untouchable.
…capable of defending your professional reputation and helping you close more deals.
If you look at it from this perspective…
Tyfon® isn’t a cost.
It’s an insurance policy for your career.
It’s a sales lever.
It’s a strategic shield.
And those who truly know it… pay for it.
€550, without blinking.
Yes, €550 is what official Onnwater distributors pay every day.
The ones NOT seeing this page.
The ones who regularly buy it at this price.
Because they know its unique value.
But today, you have a different opportunity.
Only on this page.
Only during this launch phase.
Only for those who act now.
Tyfon® is yours for just €249.
Stop for a second.
Breathe.
And think clearly.
€249… is less than the cost of a single technical service call to replace a UV lamp.
It’s less than the cost of a complaint from a customer who finds bacteria in their water.
It’s less than what you’d lose by failing to win a public tender due to missing certifications.
But above all…
€249 is an investment you can turn into €500 net profit on every installation.
You read that right. €500 is the price you can charge your clients.
With UV lamps or ozone generators…
you couldn’t even dream of those margins.
Just think about this:
how many lamps would you have to sell to make the same profit?
How many ozone generators would you need to install to reach that figure?
There’s no doubt that TYFON makes you earn more.
It helps you close more contracts.
It helps you sleep better.
Nothing else like it exists in the world.
No hygiene system for water dispensers does all this.
And certainly… not for just €249.
So now?
The final question is one:
Can you really afford NOT to have TYFON in your catalog?
It’s a bold step toward a new positioning, a new margin, a new reputation.


















Get ready now, because speed is required, indeed there is a



Because this is not a typical limited-time promo.
There will be no second chance.
And to make this choice visible and official, each water dispenser equipped with Tyfon® will come with a certified sticker showing an exclusive number:
“Tyfon® Partner 1 of 100”... “Tyfon® Partner 2 of 100”... “Tyfon® Partner 3 of 100”... and so on up to a maximum of 100 partners.
A concrete symbol to apply on the dispenser.
A seal of prestige that none of your competitors will ever be able to imitate.
But now comes the critical point…
Does 100 partners seem like a lot to you?
Onnwater already has 387 official distributors worldwide.
Many of them have already started adding Tyfon® to their catalogs.
The actual available spots are very few.
And while you are still reading, someone has already made a decision.
Actually… the probability that you are already outside the 100 exclusive Tyfon partners is extremely high, so I advise you to hurry up and call the number below to avoid watching others take the success that belonged to you.
But there is one non-negotiable condition.
A condition that — if you don’t respect it — instantly excludes you from this opportunity.
Tyfon® must be included on every single countertop dispenser you order from Onnwater.
All of them. No exceptions.
Not an add-on. Not a luxury.
It’s an identity.
If you think Tyfon® is just a “nice-to-have,” to be installed on request or “when it happens”…
Because those who REALLY want to stand out in the market, don’t do it once yes and once no.
It means taking a stand.
Actually, let me be clear:
And that also applies to your peace of mind against bacterial back-contamination.
Because if you want to protect your reputation… if you want your dispensers safe and bacteria-free you want it ALWAYS.
Not today yes and tomorrow no.
Your customers’ health is non-negotiable.
If you think these are “important but not always,” then Tyfon is not for you.
If you want to close more deals, with higher margins and zero complaints…
Then this is your chance.
Turn every dispenser you sell into a commercial leverage no competitor can replicate.
and Your Clients’ Water Tests Come Back Positive


It’s a legitimate question. Actually, it’s the right question.
But precisely because of that… I’m not asking you to take a leap of faith.
I’m asking you to make a solid decision.
And now let me tell you the truth — raw and unfiltered:
If installing an Onnwater countertop dispenser…
...following the given instructions...
...with the UV lamp at the inlet (which you get for free)…
...and with Tyfon mounted and activated…
We send an Onnwater technician directly to your location (or your client’s).
The technician inspects the entire system from top to bottom.
Replaces everything that needs to be replaced with brand new parts.
And does it completely FREE.
Until the tests come back perfectly negative.
Until your customer is fully satisfied.
Until you can sleep peacefully again.
No forms to fill out.
No procedures.
No bureaucratic red tape.
...or we take care of it until it works perfectly.
And you don’t spend a single cent more.
This is not just a guarantee.
It’s a taking of responsibility.
And it’s also why Tyfon is today the only antibacterial system for dispensers certified at medical level.
Besides… think about it for a moment:
If Tyfon really didn’t work…
...do you think Onnwater would still be here?
...do you think we could afford a guarantee like this?
...do you think we could replace systems for free without going bankrupt?
You get ALL these bonuses for FREE:











And naturally, also included is our total guarantee system:

Something inside you is already telling you that Tyfon® is exactly what you were looking for to protect your reputation, stand out in the market, and shield your business from the risks of back-contamination.
Good.
Now is the time to act.

The incoming UV lamp included for free
The video course to sell Tyfon at double the price without resistance
Personalized brochure and promo video
The certificate to give to the end customer
The physical manual “TYFON Selling Formula™” (only for the first 20)
...and much more.
You might be excluded from the 100 selected partners.
You might continue installing vulnerable systems, risking positive bacteriological tests.
Meanwhile, your competitors are reading this same page.
They’re calling.
They’re taking available spots.
Call NOW.
Become a Tyfon Partner™.
Privacy Policy | Cookies Policy | P.IVA/CF 01812830097
©2025 – Onnwater | All rigt riserved.
Privacy Policy | Cookies Policy | P.IVA/CF 01812830097
©2025 – Onnwater | All right riserved.